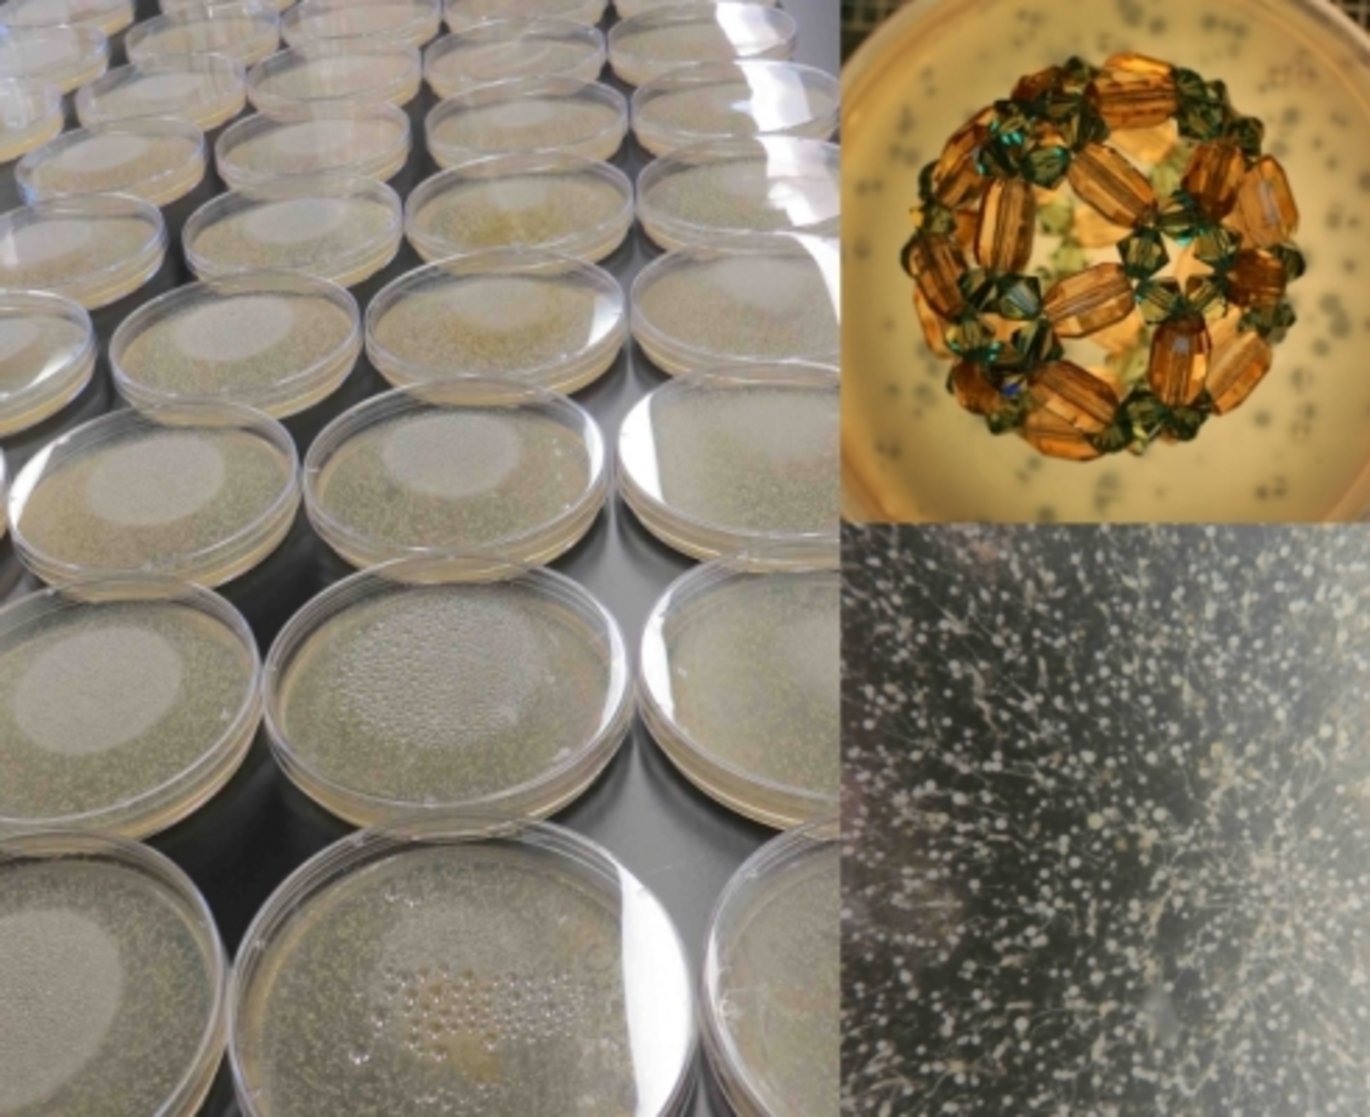

The Biology Letters 2013 special feature ‘Experimental Evolution’
The Biology Letters 2013 special feature ‘Experimental Evolution’ was organized by Thomas Bataillon from BiRC together with Paul Sniegowski and Paul Joyce.
The special feature brings together 10 invited papers in which experimental evolution is making significant progress on a variety of fundamental questions. See:
http://rsbl.royalsocietypublishing.org/content/9/1/20120945.full.pdf
